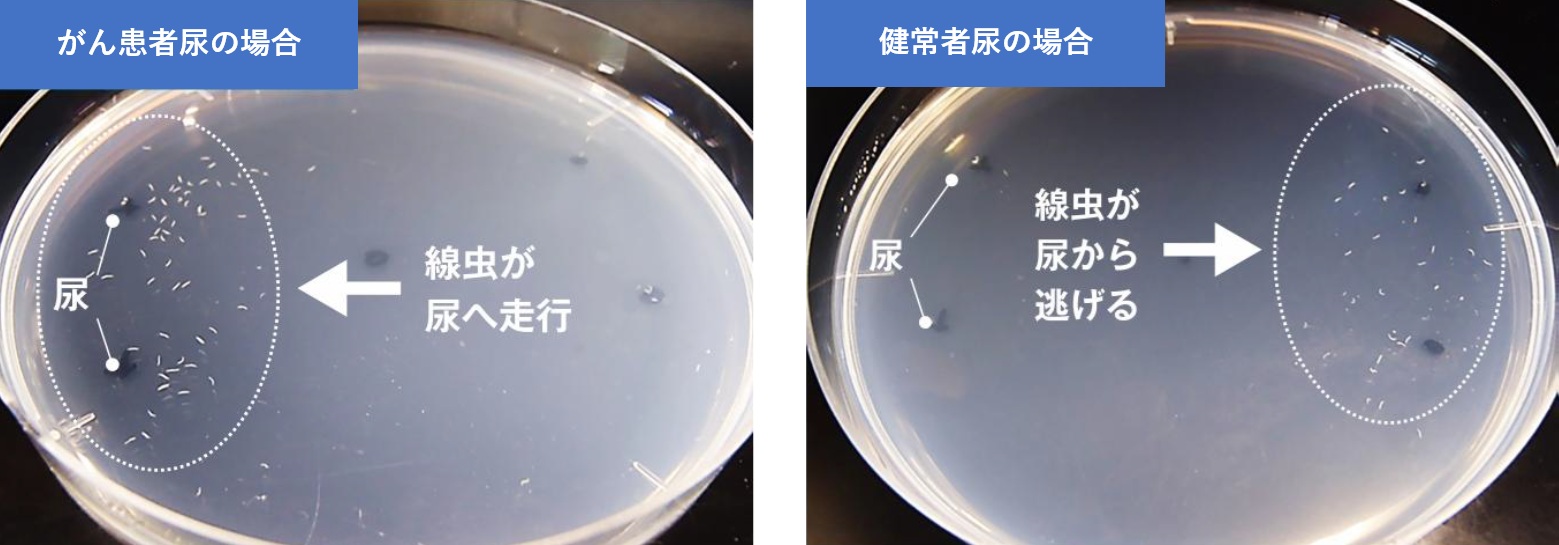
線虫がん検査 N-NOSE（エヌノーズ） | 福岡青洲会病院 | 地域医療支援

N-NOSE エヌノーズ 線虫 がん検査 癌検査 スクリーニング 尿検査 癌検診 線虫がん検査N-NOSE®の新しいカタチ 個人向け新サービス「Go To N-NOSE
(5720件)
Pontaパス特典
サンキュー配送
7500円(税込)
75ポイント(1%)
Pontaパス会員ならさらに+1%ポイント還元!
送料
(
)
5702
配送情報
お届け予定日:2026.04.22 16:28までにお届け
※一部地域・離島につきましては、表示のお届け予定日期間内にお届けできない場合があります。
ロットナンバー
4264590065
お買い物の前にチェック!

Pontaパス会員なら
ポイント+1%
ポイント+1%
商品説明


仲間由紀恵さんCMで話題のがん検査キット、N-NOSEです。\r新品未使用です。\r\r線虫N-NOSE(エヌノーズ)は、尿検査だけでできる、がんの一次スクリーニング検査用キットです。\r・ステージ1のがんリスクを判定\r・全身15種のがんに対応\r・検査が簡単 自宅で尿を採取するだけ\r・検査後も安心 アフターサービス\r\r定価 16800円 \r\r嗅覚に優れた線虫ががんの匂いに反応することを世界で初めて発見しました。\rその技術を応用して開発されたのが線虫がん検査「N-NOSE」です。発見が難しいとされているステージ1の早期がんにも反応します。\r\r6月15日に到着したばかりです。\r有効期限内ですので、安心してお使い頂けます。\r\rご不明な点がございましたらご連絡して下さい
| カテゴリー: | ダイエット・健康>>>衛生医療用品・救急用品>>>その他 |
|---|---|
| 商品の状態: | 新品、未使用","新品で購入し、一度も使用していない |
| 配送料の負担: | 送料込み(出品者負担) |
| 配送の方法: | 佐川急便/日本郵便 |
| 発送元の地域: | 大阪府 |
| 発送までの日数: | 2~3日で発送 |
レビュー
商品の評価:




 4.3点(5720件)
4.3点(5720件)
- ハルビ1103
- 別のお店のを姉妹で使用してたのですかツンツルテンになり寒そうだったのでそのお店を探したら見つからず。他も子供用って中々なく、実店舗もネットも色々探したのですがやっと出会えたこちらは、大人用で注文してたものの子供バージョンということで品質は大人用で保証済みだったので迷いなく購入。129cm細身の娘にMで膝丈、ぴったりでした。これがつんつるてんになったら大人のSにします… 色合いも可愛く好きな水色だったようで喜んでくれました。何度お洗濯してもへたったりガサガサになったりしない肌触りの良いおすすめな商品です。
- ジュニ&チヨ
- 分厚いので乾きにくいですが、色もキレイだし、可愛いです。お風呂上がりにサッと羽織らせて子供部屋まで行けるので助かっています。
- BIG0818
- デザインで悩みましたが、サイズ感もちょうどよく可愛いです。タオル地いいですね!メール便送料無料もありがたかったです。
- FNKS
- お風呂上りに便利だろうと思って 買ってあげました ママとおそろいです
- 大神Kazuo
- 糸くずがたくさんついてましたが 取り扱い説明書に 洗濯してから使用してくださいと 注意書きがあったので 大丈夫でした。 お風呂あがりにきせてます。
- ドンちゃん4132
- 全体的に汚れていたし、タオルの質もあまり良くなくて、残念な商品でした。買わなきゃよかったです。
- まゆ7167
- 今治タオルの名入れ商品を探してこちらへ。帽子付きタオルにハンカチ付きで熨斗やラッピング、手提げ袋もついてとてもお得です。ラッピング包装した上にプチプチを巻き、段ボールに入れて送ってくださいました。素晴らしすぎる!!発送手配等も早かったです。 直接持参したので中身も拝見しました。名前が見えるように箱に入ってました。友人もとても喜んでくれました。 今治マークはシール?でしたので、タグではなかったですが、証明にはなったかしら。 これから出産祝いは毎回お世話になりたいと思います。ありがとうございました!
- サバの押し鮨
- 綿100では赤ちゃんのものばかりで、この130サイズがなかなかなく、探し求めていました。 ふわっふわで早く乾くし、子供も大喜びです! 108cmの子も大きめですが問題なくむしろちょうどよくお風呂上がりに着ています。
- わかな(´ω`)
- 私はお風呂のあと服着るのが嫌だったので これならバスタオルと違い落ちたりしないので 本当に活用してます。 色違いでリピします
- tom10341227
- 吸水性がないと口コミにあったので、購入後すぐに中性洗剤に漬けて、一度洗濯してから使用しました。 ポリエステル100%なのでタオルとしての使い心地は悪いですが、拭き取るのではなく、上から押さえて吸水するように使えば、タオルとしての機能はそれなりに果たしてくれます。 ピンクを購入しました。明るいピンクで派手な印象はありますが、色落ちはなく耐久性もそこそこありそうです。
- 小鉄666
- 友人への出産祝いです。ふわふわで気持ちいい、可愛いと気に入ってもらえました。ラッピングを頼みましたが、ラッピング前の写真が同封されていたので、刺繍の仕上がりや間違いがないかのチェックができ安心して贈れました。ありがとうございました。
- sigre5476
- ふわふわで暖かいです。普段120cmですが、140cmを購入。パジャマの上に羽織る用にしたかったので、あえて大きめにしましたが、足まで隠れて暖かいので丁度よかったです。牛柄が売り切れていたのが残念。
- パパのパパ39
- 送料無料にする為に購入。夏のプールで活躍してくれますように。
- .SHIGGY
- 肌触りが非常に良いです。 買って良かったです。
- ま0105
- 白地にピンクのポンポンがついたものを購入。 かわいいし、作りも大丈夫です。 バスローブを欲しがっていた9歳の娘用です。
すべて見る
お店の情報
7,367
連絡・応対
4.3
配送スピード
4.3
梱包
4.3